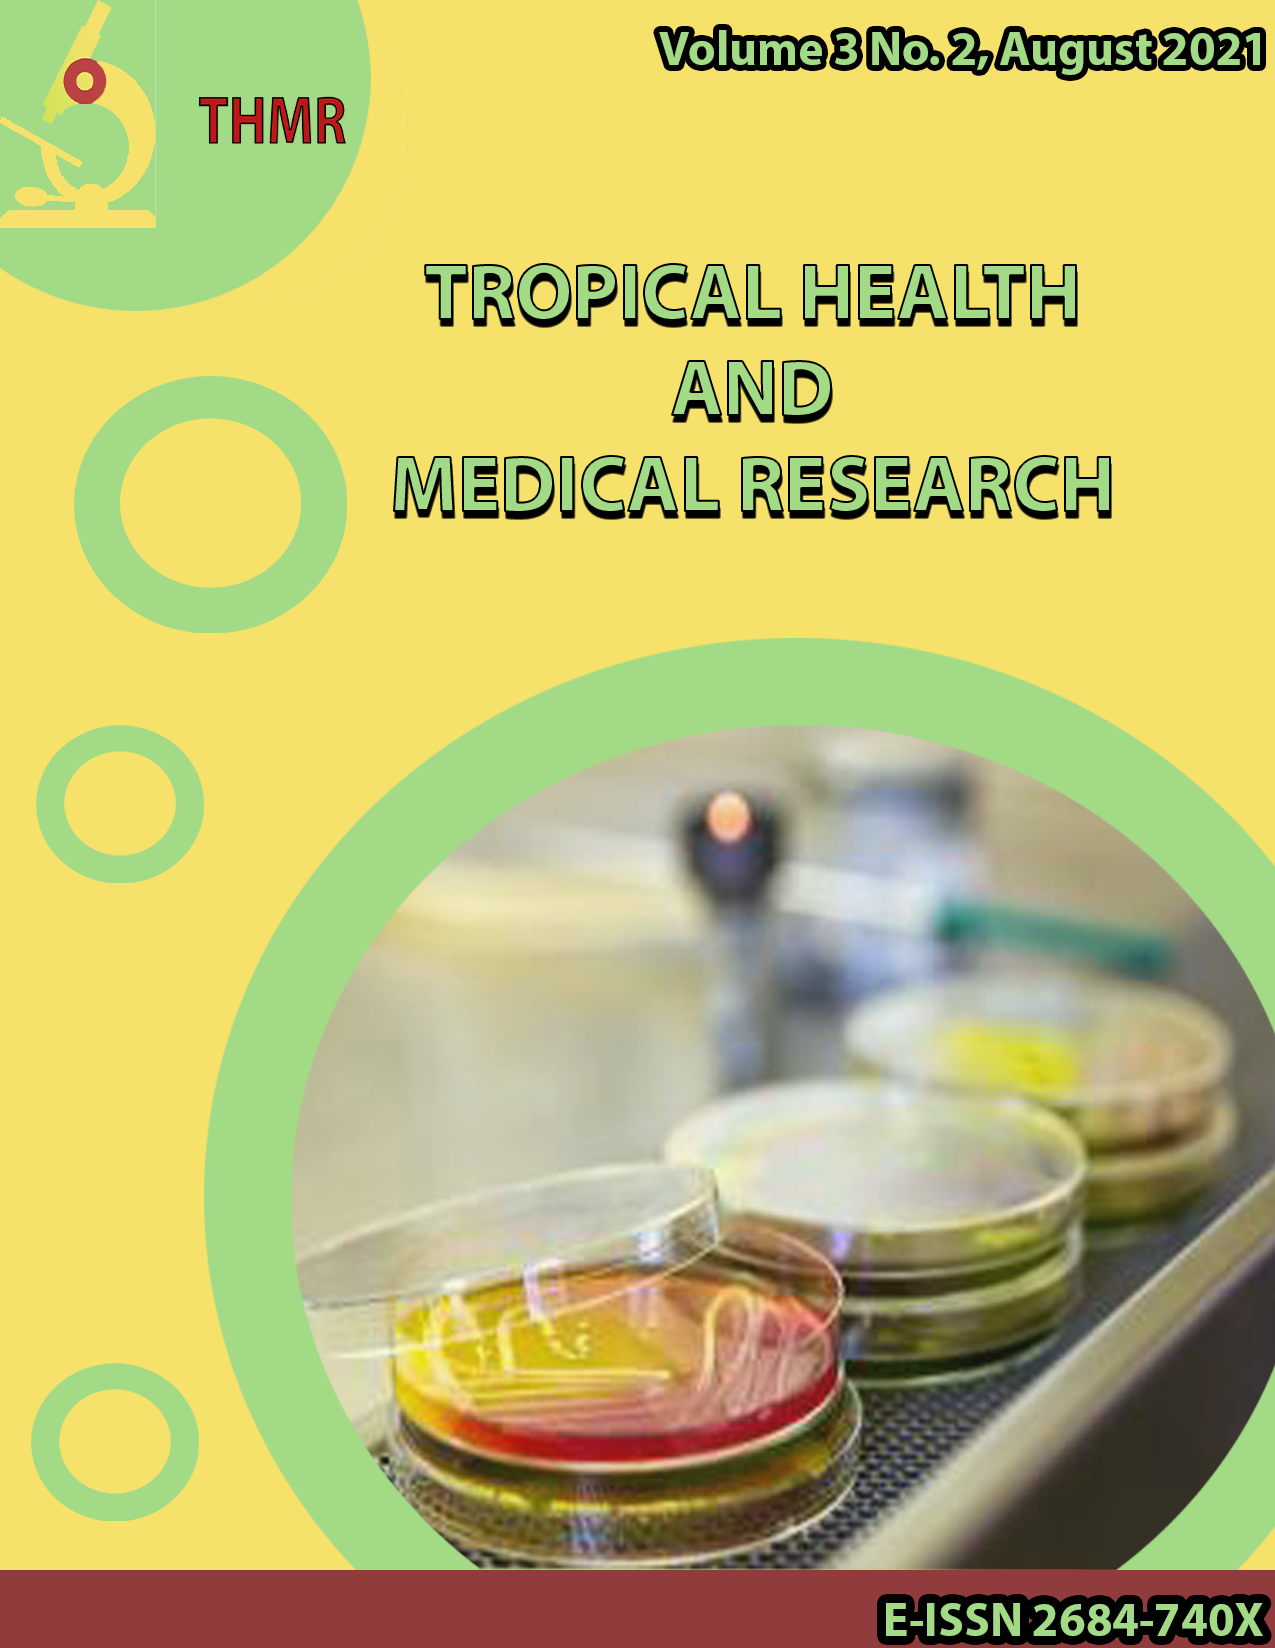
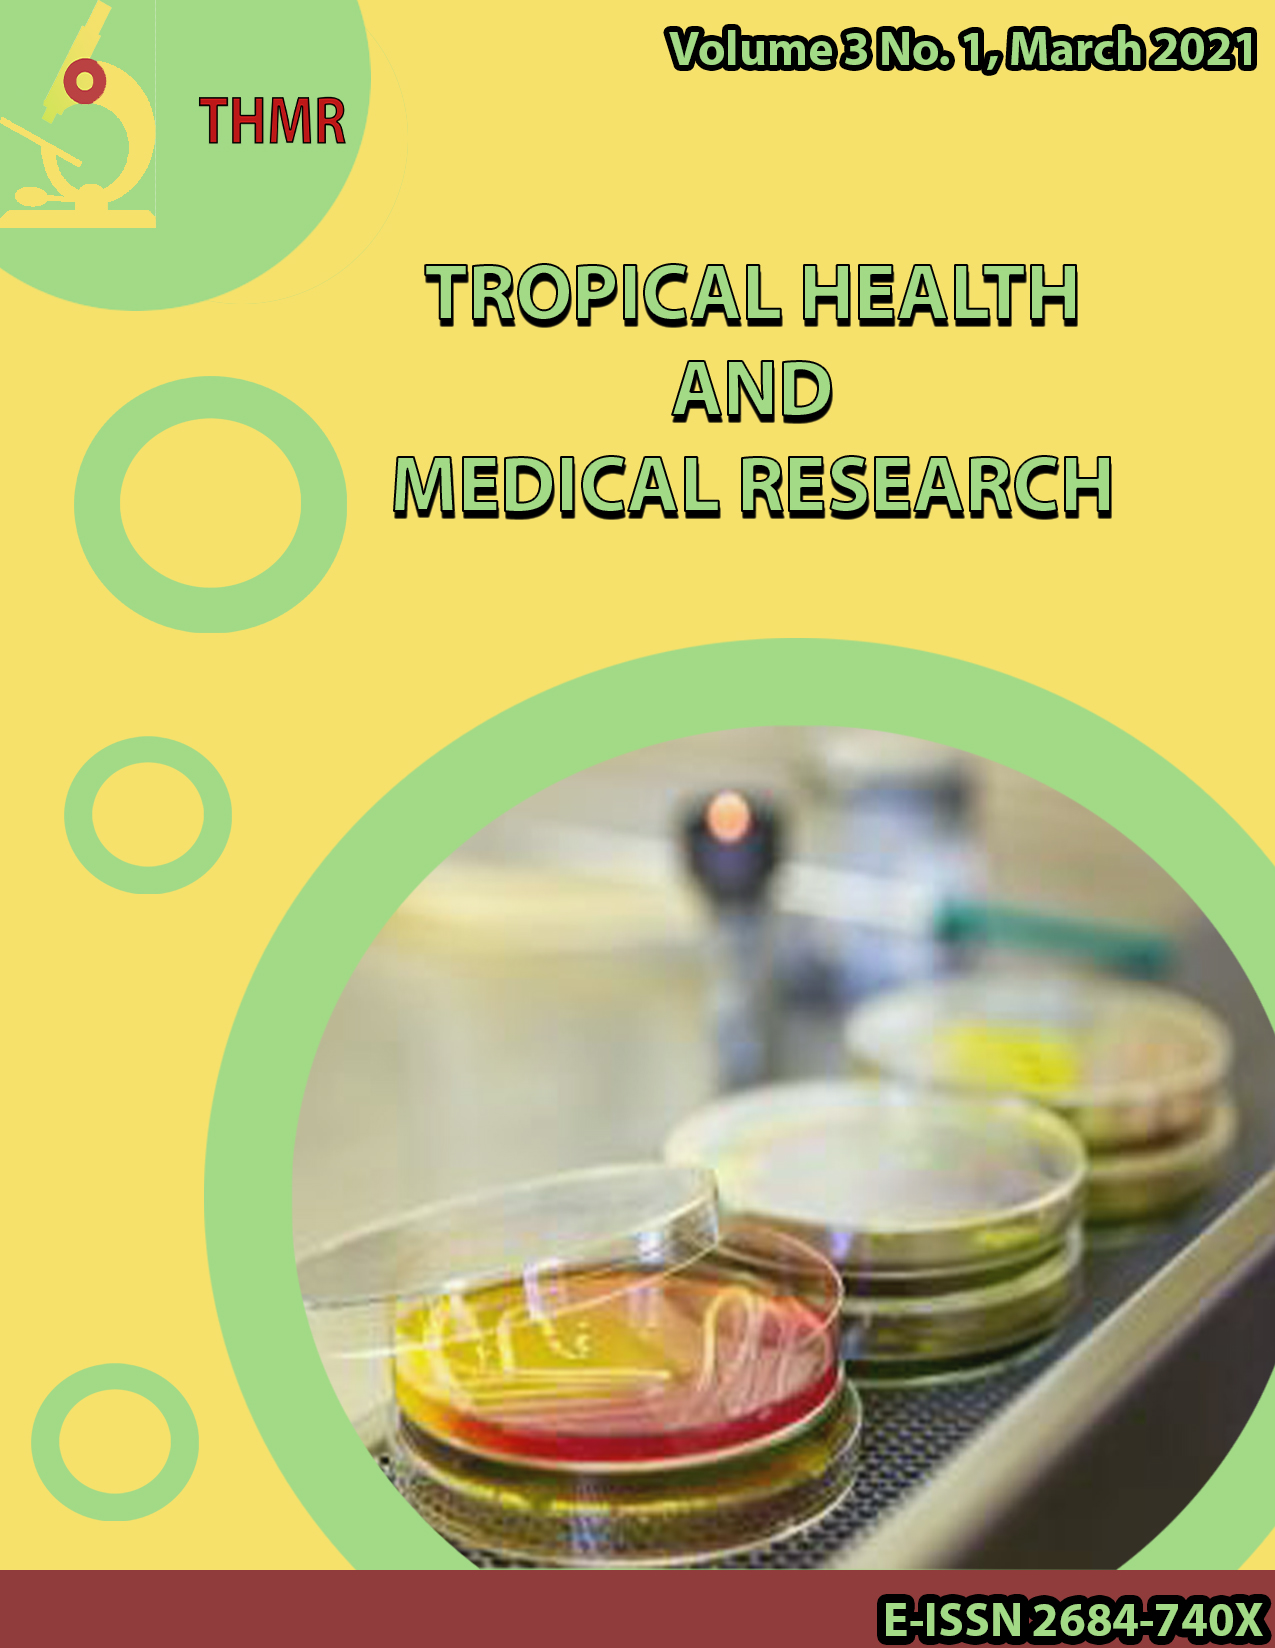

Archives
-
Tropical Health and Medical Research
Vol. 7 No. 2 (2025) -
Tropical Health and Medical Research
Vol. 7 No. 1 (2025) -
Tropical Health and Medical Research
Vol. 6 No. 2 (2024) -
Tropical Health and Medical Research
Vol. 6 No. 1 (2024)